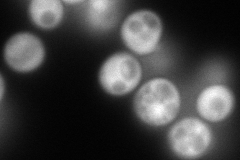
YGR024C
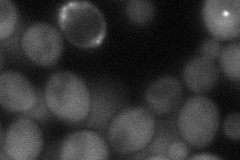
YGR024C

View description
tRNAHis guanylyltransferase, adds a guanosine residue to the 5' end of tRNAHis after transcription and RNase P cleavage; couples nuclear division and migration to cell budding and cytokinesis; essential enzyme conserved among eukaryotes
Localization:
Intensity:
Fold change:
Significance:
-
C’ GFP library in SD

cytosol23.36 -
N' NOP1pr-GFP in SD
cytosol274.689 -
N' TEF2pr-mCherry in SD

cytosol219.305 -
N' NATIVEpr-GFP in SD

below threshold20.4017 -
N' TEF2pr-VC and Cyto-VN in SD
cytosol57.7628 -
C’ GFP library in SD+DTT

cytosol23.691.01No -
C’ GFP library in SD+H2O2

cytosol19.630.84No -
C’ GFP library in Starvation Media

cytosol20.50.87No -
C’ GFP library on the background of Pup2-DaMP

cytosol -
C’ GFP library on the background of CCT mutant

cytosol23.48171.00477No
